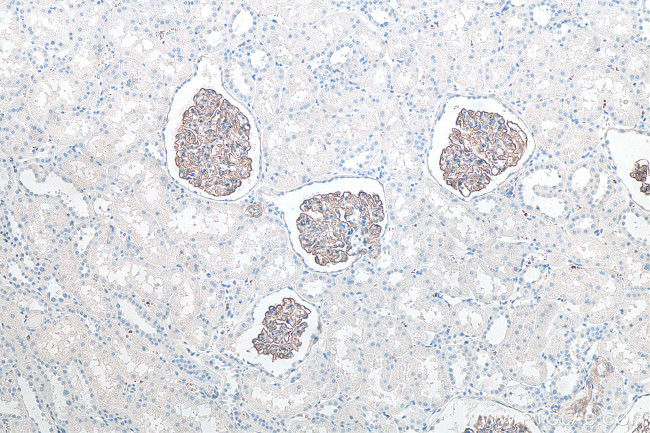
SYNPO Antibody in Immunohistochemistry (Paraffin) (IHC (P))

Search
Proteintech
SYNPO Monoclonal Antibody (1E1B1)
{{$productOrderCtrl.translations['antibody.pdp.commerceCard.promotion.promotions']}}
{{$productOrderCtrl.translations['antibody.pdp.commerceCard.promotion.viewpromo']}}
{{$productOrderCtrl.translations['antibody.pdp.commerceCard.promotion.promocode']}}: {{promo.promoCode}} {{promo.promoTitle}} {{promo.promoDescription}}. {{$productOrderCtrl.translations['antibody.pdp.commerceCard.promotion.learnmore']}}
产品信息
67339-1-IG
种属反应
宿主/亚型
分类
类型
克隆号
抗原
偶联物
形式
浓度
规格
纯化类型
保存液
内含物
保存条件
运输条件
产品详细信息
Aliquoting is unnecessary for -20°C storage.
靶标信息
SYNPO (Synaptopodin) is an actin-associated protein in telencephalic dendrites and renal podocytes. SYNPO is tightly associated with the dendritic spine apparatus, and mice lacking the SYNPO gene lack the apparatus. These SYNPO-null mice also demonstrate an impaired ability to express long-term potentiation as well as deficits in spatial memory tasks, indicating that SYNPO is involved in the regulation of synaptic plasticity. Recent studies suggest that SYNPO is linked to neuronal calcium stores and plays a role in the calcium store-associated ability of neurons to undergo long-term plasticity.
仅用于科研。不用于诊断过程。未经明确授权不得转售。
生物信息学
蛋白别名: actin associated protein; Synaptopodin; unnamed protein product
基因别名: 9030217H17Rik; 9130229N11; 9330140I15Rik; AW046661; KIAA1029; SYNPO; SYNPO1
UniProt ID: (Human) Q8N3V7, (Rat) Q9Z327
Entrez Gene ID: (Human) 11346, (Pig) 110259543, (Rat) 60324, (Mouse) 104027